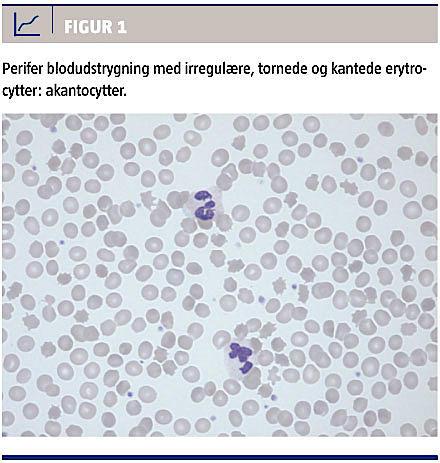

Bevægeforstyrrelser hos psykiatriske patienter skyldes sædvanligvis ekstrapyramidale bivirkninger til antipsykotisk medicin. Her beskrives en sjælden årsag til orofaciale dyskinesier, tungedystoni og koreiforme bevægelser hos en 31-årig mand i behandling for obsessiv-kompulsiv lidelse (OCD).
SYGEHISTORIE
I foråret 2010 blev en 31-årig mand af tyrkisk herkomst henvist til en neurologisk afdeling på grund af ufrivillige bevægelser i ansigts- og mundregionen gennem seks måneder. Patienten var den yngste af fire søskende og havde raske, men konsangvine forældre.
Patienten havde siden 2004 været fulgt i psykiatrisk regi for OCD med mysofobisk adfærd, der havde været forbigående til stede også i tiårsalderen. Indledningsvist blev der forsøgt behandling med quetiapin, men pga. mistanke om ekstrapyramidale bivirkninger ændrede man behandlingen til sertralin, hvilket dog ikke medførte nogen bedring.
Objektivt havde patienten betydelige orofaciale dyskinesier samt tungedystoni, der forværredes til egentlig tungeprotrusion ved fødeindtagelse. Talen var dysartrisk og ledsaget af simple vokale tics. Inspektion af mundhulen viste bidlæsioner i såvel slimhinde som tunge.
Alle kranienerver var intakte, og motoriske samt sensoriske forhold fandtes at være normale. I alle ekstremiteter fandtes hyporefleksi, mens plantarresponset var normalt bilateralt. Overekstremiteterne var plaget af asymmetriske, akrale dystonier samt koreoatetotiske bevægelser, og underekstremiteterne var medinddraget i mindre grad. Koordinationen var usikker som følge af de ufrivillige bevægelser.
En MR-skanning af hjernen og en UL-skanning af abdomen og hjerte viste normale forhold. En nerveledningsundersøgelse viste aksonal, sensorisk polyneuropati. Biokemisk fandtes kreatinkinaseniveauet at være på 5.164 U/l og laktatdehydrogenaseniveauet at være 344 U/l. Ved gentagne blodudstrygninger fandtes talrige akantocytter (Figur 1).
Mutation i DYT1 afkræftedes ved genetisk undersøgelse, mens der ved en sekventeringsanalyse af VPS13A blev påvist homozygot mutation hos patienten, der således havde choreaakantocytose (ChAc).
DISKUSSION
ChAc er en sjælden, autosomal recessiv lidelse forårsaget af mutation i VPS13A, der koder for proteinet chorein [1, 2]. Skønsmæssigt findes der på verdensplan ca. 1.000 patienter med denne lidelse.
Tilstanden kendetegnes af kantede erytrocytter, akantocytter, i blodet samt af fremadskridende degeneration af basalganglierne, særligt nucleus caudatus og putamen, der undertiden erkendes atrofierede ved billeddannende undersøgelser [1-4].
ChAc viser sig klinisk som en hyperkinetisk bevægeforstyrrelse, som ofte indledningsvist bliver fejltolket som ekstrapyramidale bivirkninger til antipsykotika, idet der hos mange patienter adskillige år tidligere er udviklet behandlingskrævende psykopatologi [1]. Hyppigst ses personlighedsændring med impulsivitet og disinhibition, emotionel labilitet, depression og OCD [1-4].
Bevægeforstyrrelsen debuterer oftest i tredje dekade med koreiforme og atetoide bevægelser i ansigtet og ekstremiteterne [1, 2, 4]. Særlig klassisk for ChAc er orofaciale dyskinesier og feeding dystonia med tungeprotusion ved fødeindtagelse samt selvmutilation af tunge, læber og kindslimhinde; hertil kommer dysartri og vokale tics [1, 2, 4].
Hypo- eller arefleksi er almindeligt forekommende og forårsages af aksonal neuropati, der kan erkendes ved elektroneuronografi [1-4]. Herudover ses myopati med distal kraftnedsættelse og muskelatrofi, samt forhøjet kreatinkinase [1-3]. Undertiden viser tilstanden sig første gang i form af epileptiske anfald med generaliseret tonisk-klonisk aktivitet, formentlig i kraft af sekundær generalisering af fokale temporallapsanfald [1-3].
Ikkeneurologiske manifestationer omfatter hepato- og spenomegali, mens kardiomyopati er en sjældenhed ved ChAc i modsætning til øvrige årsager til neuroakantocytose, eks. McLeods syndrom, pantotenatkinaseassocieret neurodegeneration og Huntington disease-like 2 (Tabel 1), der ikke skal beskrives nærmere her [1-5].

Behandlingen af ChAc er alene symptomatisk [1]. Ufrivillige bevægelser kan delvist afhjælpes ved reduktion af dopaminerg transmission ved anvendelse af atypiske antipsykotika som clozapin, quetiapin, ziprasidon og aripiprazol – herudover kan dopamindepletion med tetrabenazin være gavnligt, dog medfører behandlingen risiko for depression og parkinsonisme [1, 5]. Injektion af botulinumtoksin kan afhjælpe tungedystoni og -protrusion [1, 5].
Ergoterapeutisk evaluering af synkefunktionen er vigtig, hvad angår vurdering af behovet for ernæringssonde, og ligeledes kan diætistvejledning være relevant; ydermere kan fysioterapeutisk gang- og balancetræning være til gavn [1]. ChAc vil uvægerligt resultere i tiltagende invaliditet og reduceret levealder som følge af progredierende neurodegeneration [1, 2].
Korrespondance: Søren Bruno Elmgreen, Neurologisk Afdeling, Aarhus Universitetshospital, Nørrebrogade 44, 8000 Aarhus C. E-mail: brunonus@dadlnet.dk
Antaget: 19. september 2013
Publiceret på Ugeskriftet.dk: 20. januar 2014
Interessekonflikter:
Taksigelse: Ingolf Møller, Hæmatologisk Afdeling, Aarhus Universitetshospital, takkes for fremstilling af fotodemonstration af perifere blodudstrygninger med akantocytter.
<h2>Litteratur</h2>
<ol type="d">
<li><p>Danek A, Walker RH. Neuroacanthocytosis. Curr Opin Neurol 2005;18:386-92. </p></li>
<li><p>Danek A, Jung HH, Melone MAB et al. Neuroacanthocytosis: new developments in a neglected group of dementing disorders. J Neurol Sci 2005;229-230:171-86. </p></li>
<li><p>Hardie RJ, Pullon HW, Harding AE et al. Neuroacanthocytosis. Brain 1991;114:13-49. </p></li>
<li><p>Rampoldi L, Danek A, Monaco A. Clinical features and molecular bases of neuroacanthocytosis. J Mol Med 2002;80:475-91. </p></li>
<li><p>Jankovic J. Treatment of hyperkinetic movement disorders. Lancet Neurol 2009;8:844-56.</p></li>
</ol>
Movement disorders presenting in a psychiatric setting are usually caused by extrapyramidal side effects of antipsychotic medications. We present an unusual and rare case of orofacial dyskinesia, tongue dystonia, and choreatic movements in a 31-year-old Turkish man suffering from OCD.